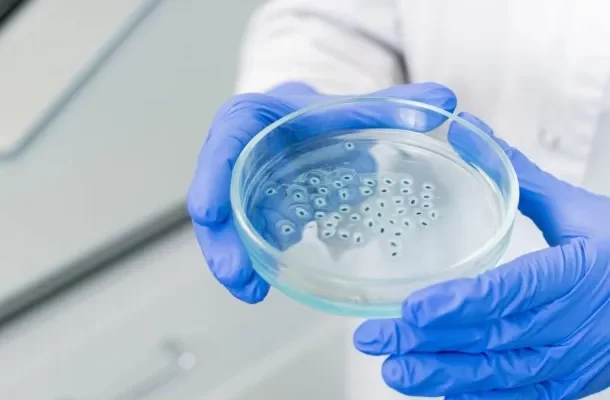

La iniciativa sancionada el mes pasado por el Congreso amplía el registro de datos genéticos con especial énfasis en el ADN de los violadores. Ahora extendió el uso de la base a todo tipo de investigación criminal.
El registro, que contará con una base de datos de perfiles genéticos y una base de datos filiatorios, funcionará para las investigaciones en el fuero federal y nacional. Por su parte, tanto las provincias como la Ciudad de Buenos Aires podrán firmar convenios para utilizarlo.
Ahora el registro permite cotejar las huellas y trazos que se obtengan en la escena del crimen con el perfil genético de los imputados y condenados, a quienes se les extraerá una muestra para sumarlo al registro.
Además, los familiares de las víctimas puedan hacer un aporte voluntario de material genético al registro y comparar el ADN del cuerpo de una persona no identificada.
Así se definió la creación del «Registro Nacional de Datos Genéticos Vinculados con la Investigación Criminal sobre la base de los perfiles genéticos de un análisis de ácido desoxirribonucleico (ADN) en las circunstancias y bajo las modalidades establecidas en la presente ley. El registro contará con una base de datos de perfiles genéticos y una base de datos filiatorios, no relacionadas entre sí. El registro funcionará para las investigaciones en el fuero federal y nacional, y las provincias y la Ciudad Autónoma de Buenos Aires podrán firmar convenios con el registro con el fin de que sus poderes judiciales y ministerios públicos puedan utilizar sus servicios».
Lo que se buscó con esta modificación es sumarle nuevas atribuciones al Registro Nacional de Datos Genéticos Vinculados a Delitos contra la Integridad Sexual (RNDG) y que no se dedique exclusivamente solo a los ofensores sexuales; por el contrario, que alcance a los familiares, siempre y cuando quieran hacer un aporte voluntario.
Sobre los datos genéticos que serán almacenados, la norma aclara que se sistematizará los siguientes perfiles:
- de asociados a la evidencia que hubiere sido obtenida en el curso de una investigación judicial y que no se encontraren vinculados con una persona ya identificada judicialmente como imputada;
- de las víctimas de un delito obtenidos en la escena del crimen, por medio de una investigación judicial, siempre que la víctima hubiera dado su consentimiento expreso. Los perfiles genéticos podrán ser retirados del registro a pedido de la víctima, en cualquier momento;
- de cadáveres o restos humanos no identificados, o material biológico presumiblemente procedente de personas extraviadas;
- de personas que, teniendo un familiar desaparecido o extraviado, acepten aportar voluntariamente una muestra biológica que pueda resultar de utilidad para la identificación genética de la persona en búsqueda;
- de una persona mayor de edad imputada, procesada o sobre la que recayese resolución judicial equivalente, o condenada en un proceso judicial o huellas que se encontraren asociadas con su identificación, así como los perfiles de quienes no fueron condenados por mediar una causa de inimputabilidad penal. En el caso de los menores de edad, sus perfiles genéticos solo podrán ser incorporados si fueron declarados penalmente responsables por la comisión de un delito.
- del personal perteneciente a las fuerzas policiales y de seguridad federales, funcionarios y empleados del Poder Judicial que intervengan en las investigaciones criminales. Cumplidos cinco (5) años desde el cese de la función policial, el agente podrá solicitar la remoción de sus datos del registro; y
- de toda persona mayor de edad que voluntariamente manifieste su deseo de incorporar su perfil genético al registro. Los perfiles genéticos de víctimas de delitos o de familiares de personas desaparecidas o extraviadas no podrán ser utilizados como muestra para el esclarecimiento de un hecho delictivo, excepto que los aportantes lo consientan expresamente.
La ley indica que, en el caso de una persona imputada, procesada o condenada sea desvinculada de la investigación a través de una resolución judicial o no se haya resuelto la situación procesal y la etapa de investigación se extienda por más de tres años, sus datos dejarán de formar parte del registro.
A su vez, indica que se priorizará el ingreso al registro de los perfiles genéticos de imputados, procesados o condenados por los delitos de homicidios dolosos, abusos sexuales y narcotráfico.
Decreto 899/2024:
Ley 27.759: